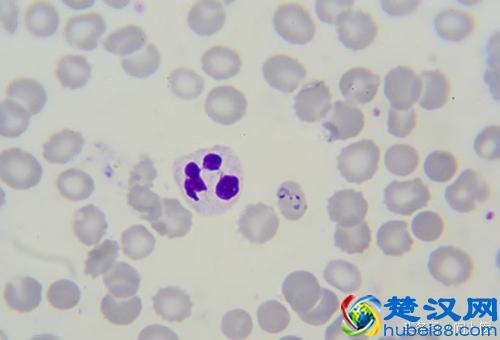
注意,这些寄生虫可能在你的身上,你却不知道!

麦地那龙线虫(狗狗麦地那龙线虫病的原因是什么)麦地那龙线虫病是由麦地那龙线虫寄生于皮下组织所引起的一种人兽共患的寄生虫病。
症状
该病的典型症状为局部皮肤出现红斑、水肿、硬结、水庖和溃疡。感染初期表现为发热、腹泻、呕吐,皮肤出现丘疹。虫体死亡继发细菌感染时症状严重,表现精神不振,呼吸困难,虚弱无力,甚至昏迷。
治疗方法
常用手术摘除。患部局麻后,手术摘除虫体,这是根治该病的主要方法。药物治疗主要用伊维菌素,也可用甲苯咪唑、丙硫咪唑和灭滴灵等。
预防措施
保持狗狗饮水的清洁卫生,改善狗狗用水的条件,在活动区域的水中,用1%双硫磷沙粒杀灭剑水蚤。
1 / 15 臭虫

家具、壁纸、床垫和杂物都是这些臭虫(小而扁平的昆虫)的筑巢点。它们喜欢住在靠近人和宠物的地方,因为它们可以在人和动物睡着时吸血。臭虫不会引起疾病,但人们可能会对它们的叮咬产生过敏反应。如果抓挠太多,被叮咬的区域可能会被感染。可以使用抗菌药膏或洗剂,或服用抗组胺剂来缓解瘙痒。
2 / 15 虱子

这些昆虫靠吸血为生。有三种类型的虱子:头虱、体虱和阴虱。只有体虱会传播疾病。因为它们是爬行的,所以可以通过与某人亲密接触感染虱子。它们会在人身上产卵,卵子孵化的时候身体就开始发痒。可以用非处方药和处方药以及洗涤剂来治疗。
3 / 15 疥疮

当螨虫钻进人的身体并进行产卵时就会导致疥疮。与感染者有皮肤接触的话就会被感染。疥疮的症状包括夜间瘙痒、皮疹、溃疡和发痒斑块。可以用一种可以杀死螨虫的处方药(杀菌剂)来治疗疥疮。
4 / 15 猪肉绦虫

吃猪肉不会感染这些绦虫,除非猪肉是生的或未煮熟的。人类和猪身上都携带了这种虫子,但如果不小心食用了被绦虫卵子污染的食物和水时,这种虫子就会传播。如果接触了体内存在绦虫的人的粪便,也会被感染。绦虫会感染肠道和大脑,从而导致囊虫病(一种引起头痛和痉挛的疾病)。有些人在没有治疗的情况下会好转,而其他人则需要药物或手术治疗。
5 / 15 食脑变形虫

相比于美国人,东南亚的人更担心这种寄生虫。这种细菌也被称为“鸟禽”,它们生活在温暖的淡水中,通过鼻子进入人体。它们会导致一种破坏脑组织的疾病,称为原发性阿米巴脑膜炎。症状包括头痛、发烧、呕吐、混乱、颈部僵硬、癫痫发作和失去平衡。现在的治疗还在试验阶段,所以存活率很低。
6 / 15 蛔虫

大多数蛔虫会感染肠道。但引起旋毛虫病的蛔虫也会影响人的肌肉。
常见蛔虫病及其症状包括:
-
蛔虫病——腹痛;
-
钩虫病——失血;
-
蛲虫感染——肛门瘙痒;
-
旋毛虫病——疼痛、发烧、脸部肿胀、眼睛粉红色以及出现皮疹;
-
鞭虫感染——粪便里有粘液、水和血液,直肠脱垂(当部分或全部直肠滑出时)。
医生可能会给患者开药以治疗这些感染。
7 / 15 贾第虫

如果曾经露营过,并出现了腹泻、胃痉挛、腹胀和恶心等症状,你很可能感染了这种细菌(贾第虫)。吃东西、喝水或者接触受感染的人或动物的粪便都会引起感染。这种病可以用处方药来治疗。
8 / 15 克氏锥虫

这种寄生虫会导致美洲锥虫病(Chagas disease),而这种疾病会危及生命。人们如果接触了含有这种细菌的粪便就会感染。症状表现为发热、疲劳、疼痛、头痛、皮疹、食欲不振、腹泻、呕吐和眼睑肿胀。之后,它会导致心脏和肠道问题。医生可以用药物治疗疾病并杀死寄生虫。
9 / 15 隐孢子虫

这种虫子也叫“秘密成员”,它会影响人的肠道。它可以通过受感染的人或动物的粪便进行传播(粪便传播)。人们很容易通过接触泳池的水而被传播,尤其是孩子。它引起的腹泻可以持续很长一段时间,但它通常可以在没有治疗的情况下自行消失。
10 / 15 恶性疟原虫
一些蚊子会携带这种会导致疟疾的寄生虫。相比于其他任何一种恶性疟原虫导致的疾病,疟疾杀死的人是最多的。感觉就像流感,疟疾会引起身体发冷、发烧、有时还会恶心或呕吐。医生必须在显微镜下观察病人的血液样本才能判断他们体内是否有恶性疟原虫。早期治疗是最好的,某些处方药可以治疗大多数恶性疟原虫引起的疾病。
11 / 15 阴道毛滴虫

这种寄生虫会导致一种叫做滴虫病的性传播疾病——一种最常见的可治愈的性传播疾病。大多数感染者没有任何症状,但有些人可能会注意到他们的阴茎或阴道有瘙痒、灼烧或刺激感。这种病可以使用抗生素治疗。
12 / 15 枯草芽孢杆菌

医生无法确定患者是如何感染这种会感染大肠的寄生虫的。有些人会胃痛和腹泻,但其他人没有症状。这在世界各地都很常见。医生可以开药帮助缓解。
13 / 15 弓形虫

这种细菌可在肉类、水中和受感染的猫的粪便中繁殖。它会引起弓形虫病,这种病有点像流感。孕妇和免疫系统弱的人可能会有严重的症状,比如肌肉、大脑和眼睛的囊肿。通常无需治疗,但是医生可以给严重的感染者开处方药。
14 / 15 麦地那龙线虫

人们如果饮用了被幼虫感染的水就会被感染。蠕虫会在胃里交配和生长,然后通过皮肤上的水泡爆发出来。症状包括发烧、肿胀和水泡附近疼痛,但通常一年之后才会出现这些迹象。这种疾病没有治疗方法。
15 / 15 寄生虫对人有好处吗?

寄生虫带给人们的都是一些坏处,但一些研究人员正试图找出它们是否也能被有益利用。对“蠕虫疗法”的研究表明,它可以帮助缓解结肠炎、克罗恩病、I型糖尿病和哮喘的症状。它在美国仍处于试验阶段。
本文地址:问答解惑频道 https://www.hkm168.com/live/133962.html,易企推百科一个免费的知识分享平台,本站部分文章来网络分享,本着互联网分享的精神,如有涉及到您的权益,请联系我们删除,谢谢!



相关阅读







